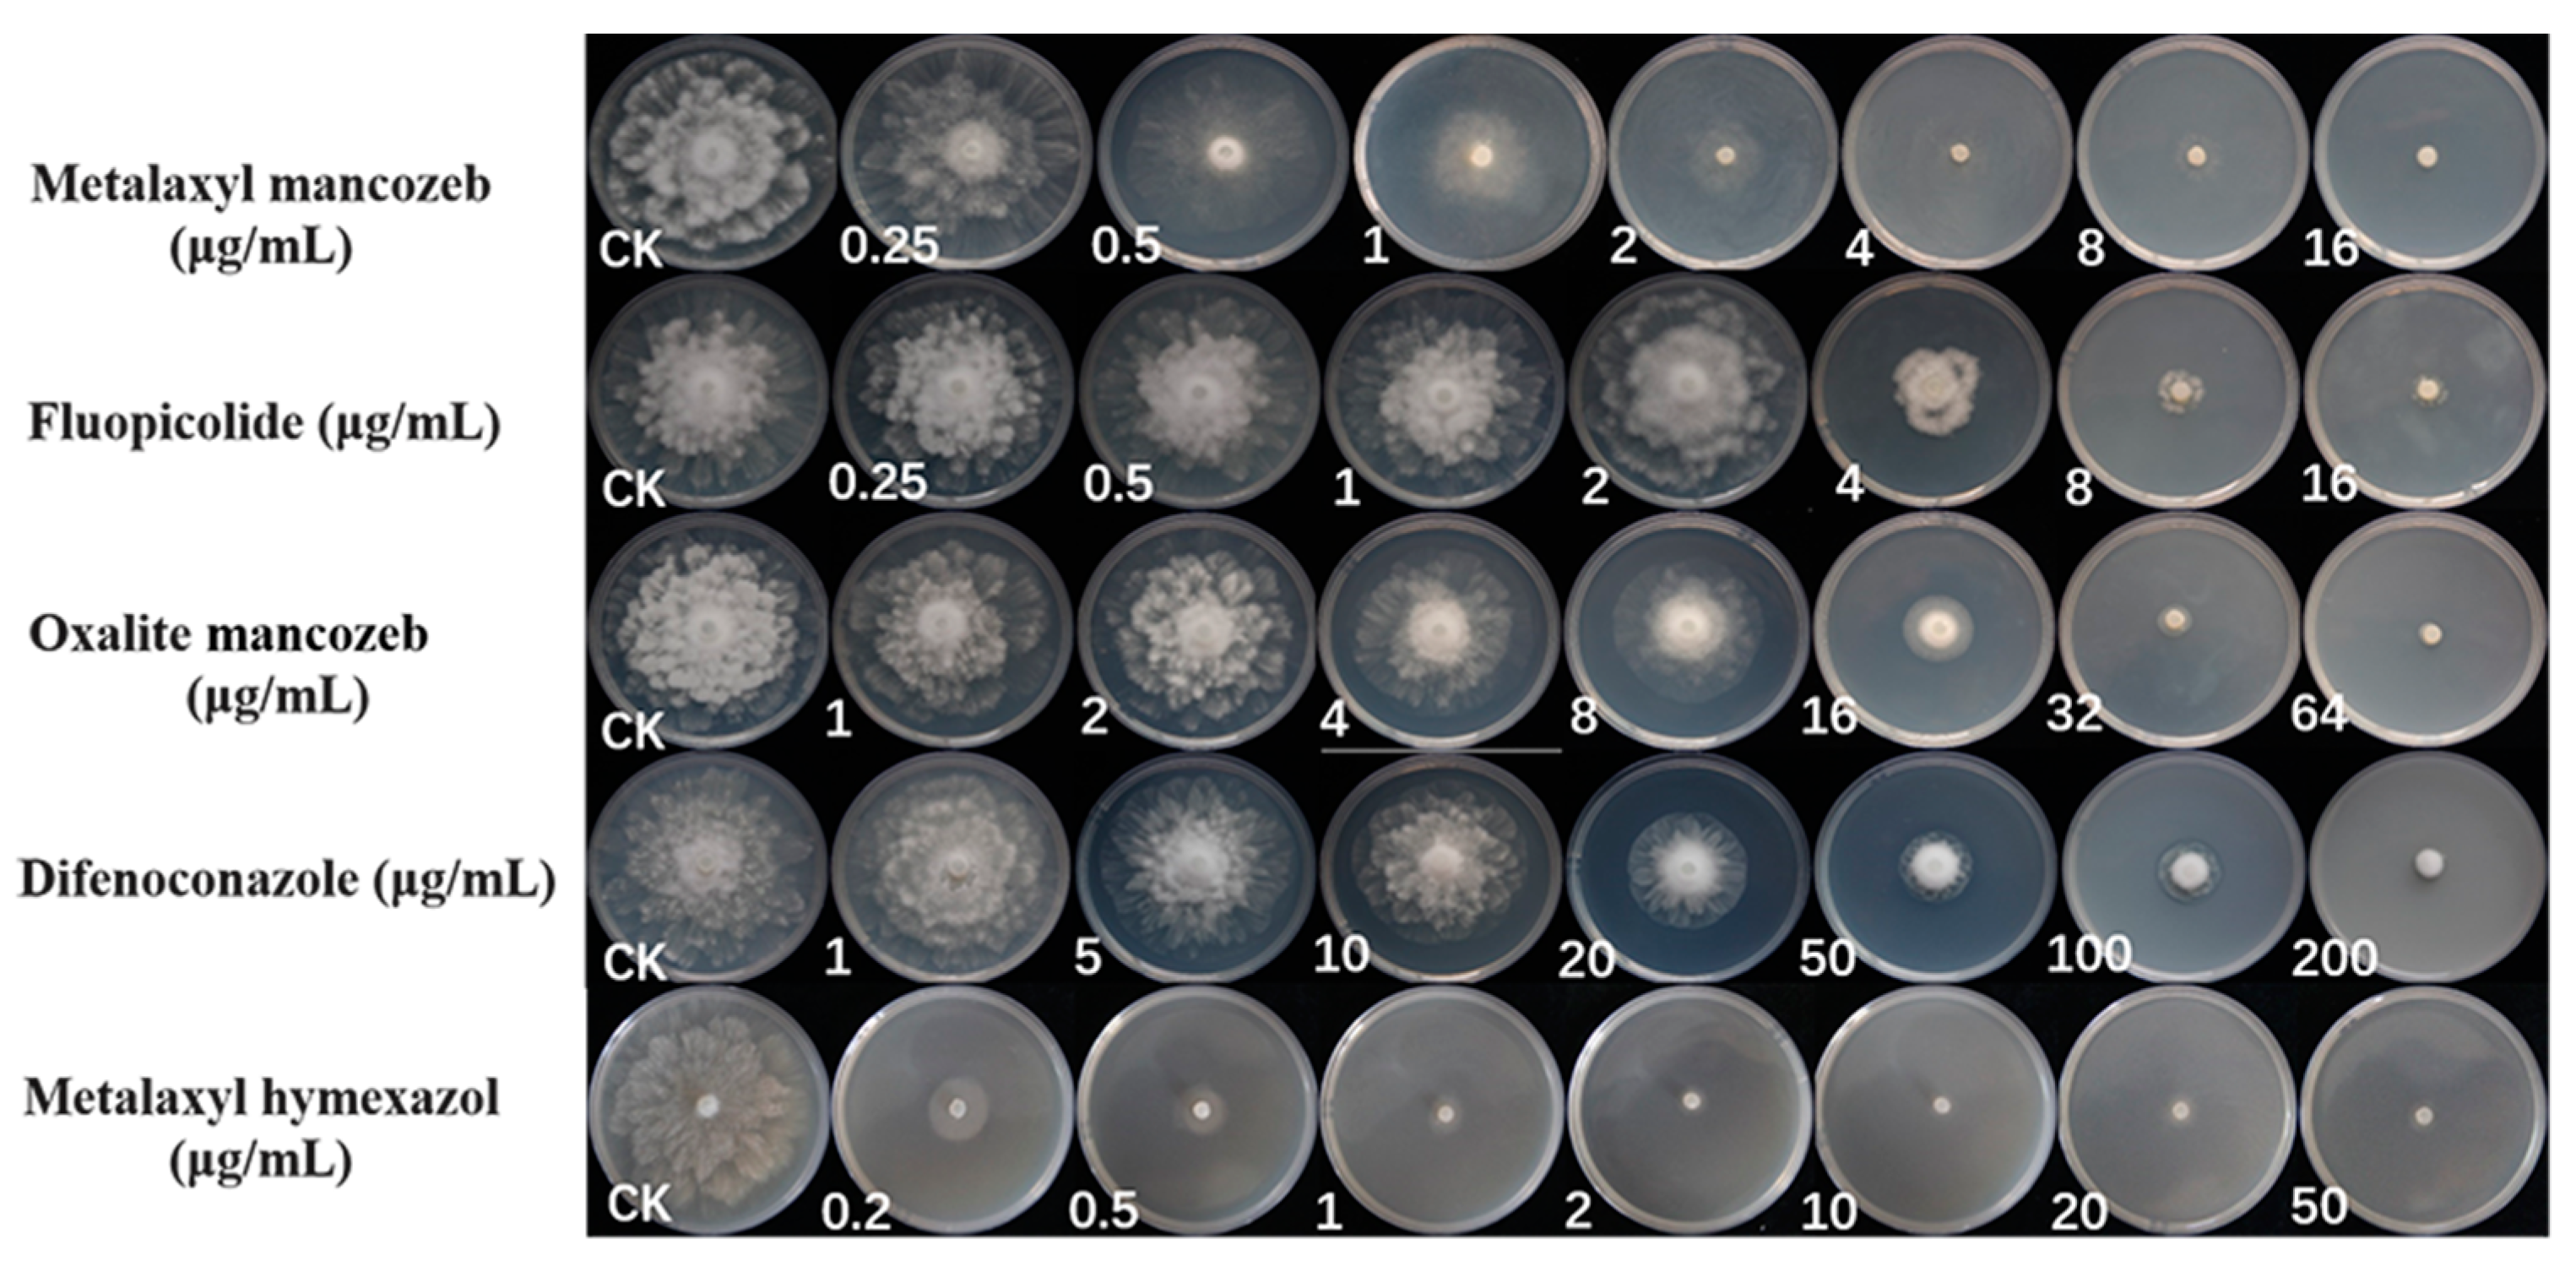
Plants 12 01072 g008

Root Rot of Cinnamomum camphora (Linn) Presl Caused by Phytopythium vexans in China
Abstract
1. Introduction
2. Results
2.1. Field Survey, Oomycete Isolation and Purification
2.2. Molecular Identification and Phylogenetic Analysis
2.3. Morphological Identification and Biological Characteristics
2.4. Pathogenicity Tests
2.5. Susceptibility of Phytopythium Isolates to Fungicides
3. Discussion
4. Materials and Methods
4.1. Field Survey, Oomycete Isolation and Purification
4.2. Molecular Identification and Phylogenetic Tree of Phytopythium sp.
4.3. Morphological Observations and Biological Characteristics
4.4. Pathogenicity Test
4.5. Susceptibility of Phytopythium Isolates to Fungicides
Author Contributions
Funding
Institutional Review Board Statement
Informed Consent Statement
Data Availability Statement
Acknowledgments
Conflicts of Interest
References
- Chen, J.; Tang, C.; Zhang, R.; Ye, S.; Zhao, Z.; Huang, Y.; Xu, X.; Lan, W.; Yang, D. Metabolomics analysis to evaluate the antibacterial activity of the essential oil from the leaves of Cinnamomum camphora (Linn.) Presl. J. Ethnopharmacol. 2020, 253, 112652. [Google Scholar] [CrossRef] [PubMed]
- Hamidpour, R.; Hamidpour, S.; Hamidpour, M.; Shahlari, M. Camphor (Cinnamomum camphora), a traditional remedy with the history of treating several diseases. Int. J. Case Rep. Images 2013, 4, 86–89. [Google Scholar] [CrossRef]
- Babu, K.N.; Sajina, A.; Minoo, D.; John, C.; Mini, P.; Tushar, K.; Rema, J.; Ravindran, P. Micropropagation of camphor tree (Cinnamomum camphora). Plant Cell Tissue Organ Cult. 2003, 74, 179–183. [Google Scholar] [CrossRef]
- Zuccarini, P. Camphor: Risks and benefits of a widely used natural product. J. Appl. Sci. Environ. Manag. 2009, 13, 69–74. [Google Scholar] [CrossRef]
- Sherkheli, M.A.; Benecke, H.; Doerner, J.F.; Kletke, O.; Vogt-Eisele, A.; Gisselmann, G.; Hatt, H. Monoterpenoids induce agonist-specific desensitization of transient receptor potential vanilloid-3 (TRPV3) ion channels. J. Pharm. Pharm. Sci. 2009, 12, 116–128. [Google Scholar] [CrossRef] [PubMed]
- Chelliah, D.A. Biological activity prediction of an ethno medicinal plant Cinnamomum camphora through bio-informatics. Ethnobot. Leafl. 2008, 2008, 22. [Google Scholar]
- Frizzo, C.D.; Santos, A.C.; Paroul, N.; Serafini, L.A.; Dellacassa, E.; Lorenzo, D.; Moyna, P. Essential oils of camphor tree (Cinnamomum camphora Nees & Eberm) cultivated in Southern Brazil. Braz. Arch. Biol. Technol. 2000, 43, 313–316. [Google Scholar] [CrossRef]
- Huang, L.-C.; Huang, B.-L.; Murashige, T. A micropropagation protocol for Cinnamomum camphora. In Vitro Cell. Dev. Biol. Plant 1998, 34, 141–146. [Google Scholar] [CrossRef]
- Chen, H.P.; Yang, K.; You, C.X.; Lei, N.; Sun, R.Q.; Geng, Z.F.; Ma, P.; Cai, Q.; Du, S.S.; Deng, Z.W. Chemical constituents and insecticidal activities of the essential oil of Cinnamomum camphora leaves against Lasioderma serricorne. J. Chem. 2014, 2014, 963729. [Google Scholar] [CrossRef]
- Judelson, H.S.; Blanco, F.A. The spores of Phytophthora: Weapons of the plant destroyer. Nat. Rev. Microbiol. 2005, 3, 47–58. [Google Scholar] [CrossRef]
- Beakes, G.W.; Glockling, S.L.; Sekimoto, S. The evolutionary phylogeny of the oomycete “fungi”. Protoplasma 2012, 249, 3–19. [Google Scholar] [CrossRef] [PubMed]
- Aubrey, Z.G. Phytophthora Cinnamomi and the Diseases it Causes; The American Phytopathological Society (PAS): St. Paul, MN, USA, 1980. [Google Scholar]
- Kucharek, T.; Mitchell, D. Diseases of Agronomic and Vegetable Crops Caused by Pythium; Plant Pathology Fact Sheet; University of Florida: Gainesville, FL, USA, 2000; p. 53. [Google Scholar]
- Wang, Y.; Tyler, B.M.; Wang, Y. Defense and counterdefense during plant-pathogenic oomycete infection. Annu. Rev. Microbiol. 2019, 73, 667–696. [Google Scholar] [CrossRef]
- Cohen, Y.; Coffey, M.D. Systemic fungicides and the control of oomycetes. Annu. Rev. Phytopathol. 1986, 24, 311–338. [Google Scholar] [CrossRef]
- Ho, H.-H. The genus Pythium in Taiwan, China (1)—A synoptic review. Front. Biol. China 2009, 4, 15–28. [Google Scholar] [CrossRef]
- Gisi, U.; Sierotzki, H. Oomycete fungicides: Phenylamides. In Fungicide Resistance in Plant Pathogens; Springer: Berlin/Heidelberg, Germany, 2015; pp. 145–174. [Google Scholar]
- Toquin, V.; Latorse, M.P.; Beffa, R. Fluopicolide: A New Anti-oomycete Fungicide. Mod. Crop Prot. Compd. 2019, 2, 871–878. [Google Scholar] [CrossRef]
- Pasteris, R.J.; Hanagan, M.A.; Bisaha, J.J.; Finkelstein, B.L.; Hoffman, L.E.; Gregory, V.; Shepherd, C.P.; Andreassi, J.L.; Sweigard, J.A.; Klyashchitsky, B.A. The discovery of oxathiapiprolin: A new, highly-active oomycete fungicide with a novel site of action. In Discovery and Synthesis of Crop Protection Products; ACS Publications: Washington, DC, USA, 2015; pp. 149–161. [Google Scholar]
- Villa, N.O.; Kageyama, K.; Asano, T.; Suga, H. Phylogenetic relationships of Pythium and Phytophthora species based on ITS rDNA, cytochrome oxidase II and β-tubulin gene sequences. Mycologia 2006, 98, 410–422. [Google Scholar] [CrossRef]
- Bala, K.; Robideau, G.; Désaulniers, N.; De Cock, A.; Lévesque, C. Taxonomy, DNA barcoding and phylogeny of three new species of Pythium from Canada. Pers.-Mol. Phylogeny Evol. Fungi 2010, 25, 22–31. [Google Scholar] [CrossRef]
- Levesque, C.A.; De Cock, A.W. Molecular phylogeny and taxonomy of the genus Pythium. Mycol. Res. 2004, 108, 1363–1383. [Google Scholar] [CrossRef]
- Uzuhashi, S.; Kakishima, M.; Tojo, M. Phylogeny of the genus Pythium and description of new genera. Mycoscience 2010, 51, 337–365. [Google Scholar] [CrossRef]
- Bala, K.; Robideau, G.; Lévesque, C.; Cock, A.; Abad, Z.; Lodhi, A.; Shahzad, S.; Ghaffar, A.; Coffey, M. Fungal planet 49. Phytopythium sindhum, gen. et sp. nov. Persoon 2010, 24, 136–137. [Google Scholar]
- Baysal-Gurel, F.; Liyanapathiranage, P.; Panth, M.; Avin, F.A.; Simmons, T. First report of Phytopythium vexans causing root and crown rot on flowering cherry in Tennessee. Plant Dis. 2021, 105, 232. [Google Scholar] [CrossRef] [PubMed]
- Boari, A.d.J.; Cunha, E.; Quadros, A.; Barreto, R.; Fernandes, A. First report of Phytopythium sp. causing storage root rot and foliage blight of cassava in Brazil. Plant Dis. 2018, 102, 1042. [Google Scholar] [CrossRef]
- Waterhouse, G.M. Key to the species of Phytophthora de Bary. Commonw. Mycol. Inst. Kew UK Mycol Pap. 1963, 92, 22. [Google Scholar]
- Van der Plaats-Niterink, A.J. Monograph of the genus Pythium. Stud. Mycol. 1981, 254–258. [Google Scholar]
- Briard, M.; Dutertre, M.; Rouxel, F.; Brygoo, Y. Ribosomal RNA sequence divergence within the Pythiaceae. Mycol. Res. 1995, 99, 1119–1127. [Google Scholar] [CrossRef]
- Matsumoto, C.; Kageyama, K.; Suga, H.; Hyakumachi, M. Phylogenetic relationships of Pythium species based on ITS and 5.8 S sequences of the ribosomal DNA. Mycoscience 1999, 40, 321–331. [Google Scholar] [CrossRef]
- PanabiÈRes, F.; Ponchet, M.; Allasia, V.; Cardin, L.; Ricci, P. Characterization of border species among Pythiaceae: Several Pythium isolates produce elicitins, typical proteins from Phytophthora spp. Mycol. Res. 1997, 101, 1459–1468. [Google Scholar] [CrossRef]
- Martin, F.N. Phylogenetic relationships among some Pythium species inferred from sequence analysis of the mitochondrially encoded cytochrome oxidase II gene. Mycologia 2000, 92, 711–727. [Google Scholar] [CrossRef]
- Petersen, A.B.; Rosendahl, S. Phylogeny of the Peronosporomycetes (Oomycota) based on partial sequences of the large ribosomal subunit (LSU rDNA). Mycol. Res. 2000, 104, 1295–1303. [Google Scholar] [CrossRef]
- Voglmayr, H. Phylogenetic relationships of Peronospora and related genera based on nuclear ribosomal ITS sequences. Mycol. Res. 2003, 107, 1132–1142. [Google Scholar] [CrossRef] [PubMed]
- Panth, M.; Baysal-Gurel, F.; Avin, F.A.; Simmons, T. Identification and chemical and biological management of Phytopythium vexans, the causal agent of Phytopythium root and crown rot of woody ornamentals. Plant Dis. 2021, 105, 1091–1100. [Google Scholar] [CrossRef]
- Tewoldemedhin, Y.T.; Mazzola, M.; Botha, W.J.; Spies, C.F.; McLeod, A. Characterization of fungi (Fusarium and Rhizoctonia) and oomycetes (Phytophthora and Pythium) associated with apple orchards in South Africa. Eur. J. Plant Pathol. 2011, 130, 215–229. [Google Scholar] [CrossRef]
- Polat, Z.; Awan, Q.; Hussain, M.; Akgül, D.S. First report of Phytopythium vexans causing root and collar rot of kiwifruit in Turkey. Plant Dis. 2017, 101, 1058. [Google Scholar] [CrossRef]
- Yu, Y.-T.; Chen, J.; Gao, C.-S.; Zeng, L.-B.; Li, Z.-M.; Zhu, T.-T.; Sun, K.; Cheng, Y.; Sun, X.-P.; Yan, L. First report of brown root rot caused by Pythium vexans on ramie in Hunan, China. Can. J. Plant Pathol. 2016, 38, 405–410. [Google Scholar] [CrossRef]
- Park, M.-J.; Back, C.-G.; Park, J.-H. Occurrence of Phytopythium vexans Causing Stem Rot on Anthurium andraeanum in Korea. Korean J. Mycol. 2019, 47, 443–446. [Google Scholar] [CrossRef]
- Bonde, M.; Nester, S.; Berner, D. Effects of daily temperature highs on development of Phakopsora pachyrhizi on soybean. Phytopathology 2012, 102, 761–768. [Google Scholar] [CrossRef]
- Cantrell, H.; Dowler, W. Effects of temperature and pH on growth and composition of Pythium irregulare and Pythium vexans. Mycologia 1971, 63, 31–37. [Google Scholar] [CrossRef] [PubMed]
- Zeng, H.; Ho, H.; Zheng, F. Pythium vexans causing patch canker of rubber trees on Hainan Island, China. Mycopathologia 2005, 159, 601–606. [Google Scholar] [CrossRef] [PubMed]
- Delmas, C.E.; Mazet, I.D.; Jolivet, J.; Delière, L.; Delmotte, F. Simultaneous quantification of sporangia and zoospores in a biotrophic oomycete with an automatic particle analyzer: Disentangling dispersal and infection potentials. J. Microbiol. Methods 2014, 107, 169–175. [Google Scholar] [CrossRef]
- Beluzán, F.; Miarnau, X.; Torguet, L.; Armengol, J.; Abad-Campos, P. Survey of Oomycetes Associated with Root and Crown Rot of Almond in Spain and Pathogenicity of Phytophthora niederhauserii and Phytopythium vexans to ‘Garnem’ Rootstock. Agriculture 2022, 12, 294. [Google Scholar] [CrossRef]
- Panth, M.; Hassler, S.C.; Baysal-Gurel, F. Methods for management of soilborne diseases in crop production. Agriculture 2020, 10, 16. [Google Scholar] [CrossRef]
- Feng, H.; Chen, J.; Yu, Z.; Li, K.; Li, Z.; Li, Y.; Sun, Z.; Wang, Y.; Ye, W.; Zheng, X. Pathogenicity and fungicide sensitivity of Pythium and Phytopythium spp. associated with soybean in the Huang-Huai region of China. Plant Pathol. 2020, 69, 1083–1092. [Google Scholar] [CrossRef]
- Vargas, A.; Paul, P.A.; Winger, J.; Balk, C.S.; Eyre, M.; Clevinger, B.; Noggle, S.; Dorrance, A.E. Oxathiapiprolin alone or mixed with metalaxyl seed treatment for management of soybean seedling diseases caused by species of Phytophthora, Phytopythium, and Pythium. Plant Dis. 2022, 106, 2127–2137. [Google Scholar] [CrossRef] [PubMed]
- Erwin, D.C.; Ribeiro, O.K. Phytophthora Diseases Worldwide; American Phytopathological Society (APS Press): St. Paul, MN, USA, 1996. [Google Scholar]
- Tsao, P.H. Factors affecting isolation and quantitation of Phytophthora from soil. Phytophthora Biol. Taxon. Ecol. Pathol. 1983, 219–236. [Google Scholar]
- Möller, E.; Bahnweg, G.; Sandermann, H.; Geiger, H. A simple and efficient protocol for isolation of high molecular weight DNA from filamentous fungi, fruit bodies, and infected plant tissues. Nucleic Acids Res. 1992, 20, 6115. [Google Scholar] [CrossRef]
- Tamura, K.; Stecher, G.; Peterson, D.; Filipski, A.; Kumar, S. MEGA6: Molecular evolutionary genetics analysis version 6.0. Mol. Biol. Evol. 2013, 30, 2725–2729. [Google Scholar] [CrossRef]
- Nguyen, L.-T.; Schmidt, H.A.; Von Haeseler, A.; Minh, B.Q. IQ-TREE: A fast and effective stochastic algorithm for estimating maximum-likelihood phylogenies. Mol. Biol. Evol. 2015, 32, 268–274. [Google Scholar] [CrossRef]
- Ronquist, F.; Teslenko, M.; Van Der Mark, P.; Ayres, D.L.; Darling, A.; Höhna, S.; Larget, B.; Liu, L.; Suchard, M.A.; Huelsenbeck, J.P. MrBayes 3.2: Efficient Bayesian phylogenetic inference and model choice across a large model space. Syst. Biol. 2012, 61, 539–542. [Google Scholar] [CrossRef]

| Isolates | EC50 Values (μg/mL) | ||||
|---|---|---|---|---|---|
| Metalaxyl Mancozeb | Metalaxyl Hymexazol | Fluopicolide | Difenoconazole | Oxalite Mancozeb | |
| ZS01 | 1.31 ± 0.01 | 0.003 ± 0.002 | 2.55 ± 0.14 | 17.38 ± 3.56 | 8.32 ± 1.04 |
| ZS02 | 1.29 ± 0.01 | 0.002 ± 0.002 | 2.35 ± 0.02 | 15.90 ± 2.88 | 9.40 ± 1.33 |
| ZS03 | 1.30 ± 0.12 | 0.011 ± 0.004 | 2.62 ± 0.01 | 17.09 ± 3.24 | 10.23 ± 0.98 |
| ZS04 | 1.28 ± 0.07 | 0.019 ± 0.001 | 2.50 ± 0.01 | 18.68 ± 3.66 | 7.88 ± 1.11 |
| Primer | Sequence (5′-3′) | PCR Conditions |
|---|---|---|
| ITS1 ITS4 | TCCGTAGGTGAACCTGCGG TCCTCCGCTTATTGATATGC | Denaturation for 3 min at 94 °C, followed by 35 cycles; 30 s at 94 °C, 30 s at 55 °C, 60 s at 72 °C, and 10 min of a final extension at 70 °C |
| Coxlevup Coxlevlo | TCAWCWMGATGGCTTTTTTCAAC CYTCHGGRTGWCCRAAAAACCAAA | Denaturation for 3 min at 94 °C, followed by 35 cycles; 30 s at 94 °C, 30 s at 53 °C, 60 s at 72 °C, and 10 min of a final extension at 70 °C |
| CoxII-F CoxII-Rc4 | GGCAAATGGGTTTTCAAGATCC TGATTWAYNCCACAAATTTCRCTACATTG | Denaturation for 3 min at 94 °C, followed by 35 cycles; 30 s at 94 °C, 30 s at 53 °C, 60 s at 72 °C, and 10 min of a final extension at 70 °C |
| NL1 NL4 | GCATATCAATAAGCGGAGGAAAAG GGTCCGTGTTTCAAGACGG | Denaturation for 3 min at 94 °C, followed by 35 cycles; 30 s at 94 °C, 30 s at 55 °C, 60 s at 72 °C, and 10 min of a final extension at 70 °C |
| Btub-F1A Btub-R1A | GCCAAGTTCTGGGARGTSAT CCTGGTACTGCTGGTAYTCMGA | Denaturation for 5 min at 94 °C, followed by 35 cycles; 30 s at 94 °C, 30 s at 60 °C, 60 s at 72 °C, and 10 min of a final extension at 70 °C |
| Species | Isolates | GenBank Accession Numbers | ||||
|---|---|---|---|---|---|---|
| rDNA ITS | LSU rDNA | coxI | coxII | β-tubulin | ||
| P. aichiense | CBS 137195 | AB948197 | AB948194 | AB948191 | AB948192 | AB948170 |
| P. chamaehyphon | CBS 25930 | AB690609 | AB690593 | AB690644 | AB690674 | AB948188 |
| P. carbonicum | CBS 112544 | AB725876 | AB996605 | AB690648 | AB690678 | AB948183 |
| P. citrinum | CBS 119171 | AY197328 | AB690597 | AB690649 | AB690679 | AB948180 |
| P. cucurbitacearum | CBS 7496 | AB725877 | AB690598 | AB690650 | AB690680 | AB948189 |
| P. delawarense | 382B | AB725875 | AB690591 | AB690642 | AB690672 | AB948181 |
| P. helicoides | CBS 28631 | AB725878 | AB690594 | AB690645 | AB690675 | AB948187 |
| H5 | AB690611 | AB690582 | AB690633 | AB690663 | AB948186 | |
| P. iriomotense | GUCC0025 | AB690622 | AB690600 | AB690652 | AB690682 | AB948172 |
| GUCC0028 | AB690623 | AB690601 | AB690653 | AB690683 | AB948171 | |
| GUCC0036 | AB690624 | AB690602 | AB690654 | AB690684 | AB948173 | |
| CBS 137104 | AB690629 | AB690607 | AB690659 | AB690689 | AB948174 | |
| P. litorale | NBRC107451 | AB690612 | AB690583 | AB690634 | AB690664 | AB948182 |
| CBS 118360 | HQ643386 | HQ665082 | HQ708433 | KJ595418 | NA | |
| P. mercuriale | CBS 122443 | AB725882 | AB690585 | AB690636 | AB690666 | AB948179 |
| P. montanum | CBS 111349 | AB725883 | AB690586 | AB690637 | AB690667 | AB948184 |
| P. oedochilum | CBS 25270 | AB690618 | AB690592 | AB690643 | AB690673 | AB948175 |
| CBS 29237 | AB690619 | AB690595 | AB690646 | AB690676 | NA | |
| GUCC5091 | AB920534 | NA | AB920493 | AB920500 | NA | |
| P. ostracodes | CBS 76873 | AY598663 | AB690587 | AB690638 | AB690668 | AB948178 |
| P. megacarpum | CBS 112351 | HQ643388 | HQ665067 | HQ708435 | AB690665 | NA |
| P. boreale | CBS 55188 | HQ643372 | HQ665261 | HQ708419 | AB690677 | NA |
| P. mirpurense | CBS 124523 | KJ831613 | KJ831613 | KJ831612 | NA | NA |
| P. vexans | NBRC107442 | AB690626 | AB690604 | AB690656 | AB690686 | NA |
| NBRC107393 | AB690630 | AB690608 | AB690660 | AB690690 | NA | |
| NBRC107380 | AB690627 | AB690605 | AB690657 | AB690687 | NA | |
| NBRC107381 | AB690628 | AB690606 | AB690658 | AB690688 | NA | |
| NBRC107397 | AB690610 | AB690581 | AB690632 | AB690662 | NA | |
| CBS 11980 | HQ643400 | HQ665090 | HQ708447 | GU133518 | NA | |
| P133 | MT740895 | MT729990 | MT720669 | MT720685 | NA | |
| 2D111 | AB725880 | AB856796 | AB856784 | AB948193 | AB948169 | |
| ZS01 | OM663739 | OP159402 | OM791301 | OM791302 | OP185088 | |
| ZS02 | OM663740 | OP159403 | OM791303 | OM791304 | OP185089 | |
| ZS03 | OM663741 | OP159404 | OM791305 | OM791306 | OP185090 | |
| ZS04 | OM663742 | OP159405 | OM791307 | OM791308 | OP185091 | |
| ZS05 | OP941721 | OP947167 | OP948802 | OP948803 | OP948801 | |
| ZS06 | OP941722 | OP947168 | OP948805 | OP948806 | OP948804 | |
| ZS07 | OP941723 | OP947169 | OP948808 | OP948809 | OP948807 | |
| ZS08 | OP941724 | OP947170 | OP948811 | OP948812 | OP948810 | |
| ZS09 | OP941725 | OP947171 | OP948814 | OP948815 | OP948813 | |
| ZS10 | OP941726 | OP947172 | OP948817 | OP948818 | OP948816 | |
| ZS11 | OP941727 | OP947173 | OP948820 | OP948821 | OP948819 | |
| ZS12 | OP941728 | OP947174 | OP948823 | OP948824 | OP948822 | |
| ZS13 | OP941729 | OP947175 | OP948826 | OP948827 | OP948825 | |
| ZS14 | OP941730 | OP947176 | OP948829 | OP948830 | OP948828 | |
| ZS15 | OP941731 | OP947177 | OP948832 | OP948833 | OP948831 | |
| ZS16 | OP941732 | OP947178 | OP948835 | OP948836 | OP948834 | |
| ZS17 | OP941733 | OP947179 | OP948838 | OP948839 | OP948837 | |
| ZS18 | OP941734 | OP947180 | OP948841 | OP948842 | OP948840 | |
| ZS19 | OP941735 | OP947181 | OP948844 | OP948845 | OP948843 | |
| ZS20 | OP941736 | OP947182 | OP948847 | OP948848 | OP948846 | |
| ZS21 | OP941737 | OP947183 | OP948850 | OP948851 | OP948849 | |
| ZS22 | OP941738 | OP947184 | OP948853 | OP948854 | OP948852 | |
| ZS23 | OP941739 | OP947185 | OP948856 | OP948857 | OP948855 | |
| ZS24 | OP941740 | OP947186 | OP948859 | OP948860 | OP948858 | |
| ZS25 | OP941741 | OP947187 | OP948862 | OP948863 | OP948861 | |
| ZS26 | OP941742 | OP947188 | OP948865 | OP948866 | OP948864 | |
| ZS27 | OP941743 | OP947189 | OP948868 | OP948869 | OP948867 | |
| ZS28 | OP941744 | OP947190 | OP948871 | OP948872 | OP948870 | |
| ZS29 | OP941745 | OP947191 | OP948874 | OP948875 | OP948873 | |
| ZS30 | OP941746 | OP947192 | OP948877 | OP948878 | OP948876 | |
| Phytophthora nicotianae | GF101 | AB688384 | AB688538 | AB688265 | NA | AB948190 |
Disclaimer/Publisher’s Note: The statements, opinions and data contained in all publications are solely those of the individual author(s) and contributor(s) and not of MDPI and/or the editor(s). MDPI and/or the editor(s) disclaim responsibility for any injury to people or property resulting from any ideas, methods, instructions or products referred to in the content. |
© 2023 by the authors. Licensee MDPI, Basel, Switzerland. This article is an open access article distributed under the terms and conditions of the Creative Commons Attribution (CC BY) license (https://creativecommons.org/licenses/by/4.0/).
Share and Cite
Xiao, Y.; Li, M.; Chen, F. Root Rot of Cinnamomum camphora (Linn) Presl Caused by Phytopythium vexans in China. Plants 2023, 12, 1072. https://doi.org/10.3390/plants12051072
Xiao Y, Li M, Chen F. Root Rot of Cinnamomum camphora (Linn) Presl Caused by Phytopythium vexans in China. Plants. 2023; 12(5):1072. https://doi.org/10.3390/plants12051072
Chicago/Turabian StyleXiao, Yatong, Min Li, and Fengmao Chen. 2023. "Root Rot of Cinnamomum camphora (Linn) Presl Caused by Phytopythium vexans in China" Plants 12, no. 5: 1072. https://doi.org/10.3390/plants12051072
APA StyleXiao, Y., Li, M., & Chen, F. (2023). Root Rot of Cinnamomum camphora (Linn) Presl Caused by Phytopythium vexans in China. Plants, 12(5), 1072. https://doi.org/10.3390/plants12051072

